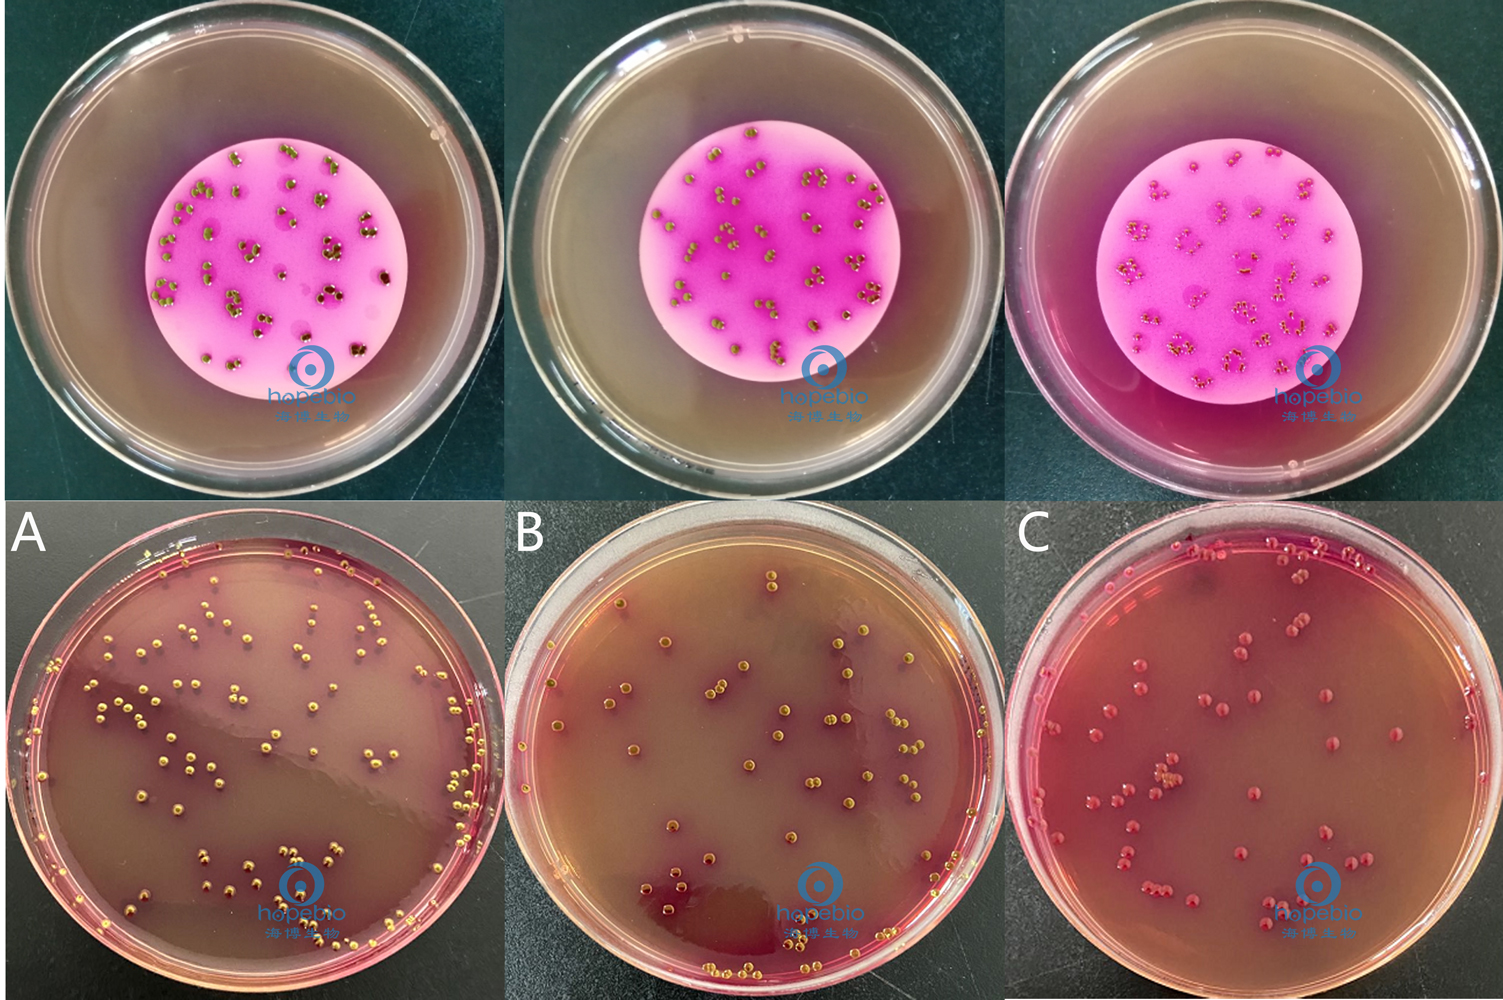

海博微信公众号
海博天猫旗舰店




一、大肠菌群简介
大肠菌群是革兰氏阴性、无芽孢、氧化酶阴性的杆状细菌,为需氧和兼性厌氧,可在有胆盐(或具有其他抑制生长的表面活性剂)存在的情况下生长,通常可在36℃士2℃发酵乳糖并产酸和醛。主要由肠杆菌科中四个属内的一些细菌所组成,即埃希氏菌属、柠檬酸杆菌属、克雷伯氏菌属以及肠杆菌属。
大肠菌群主要来源于人畜粪便,故以此作为粪便污染指标来评价食品的卫生质量,推断食品中有否污染肠道致病菌的可能。如果大肠菌群存在于食品中,表明未作有效的消毒处理、加工后保存条件不良或消毒后又受到污染。快速检验这些细菌,有助于食品的卫生管理,维护消费者的食用安全。
二、参考标准
《GB8538-2016 饮用天然矿泉水:大肠菌群检验》
三、检验原理
3.1 多管发酵法
根据大肠菌群细菌具有的生物特性,如革兰氏阴性无芽孢杆菌,在37℃培养24h能发酵乳糖并产气的特点,将不同量的水样接种到含乳糖的培养基中,经培养后根据阳性反应结果可测出原水样中大肠菌群的最可能数(MPN)。
3.2 滤膜法
采用孔径为0.45μm水相微孔薄膜,将水中所含的细菌截留在滤膜上,然后将滤膜贴在选择性鉴别培养基上,经37℃培养24h后,大肠菌群细菌在滤膜上长出具有特征性的菌落,直接计数典型菌落数,计算出每100mL水样中所含的大肠菌群数。
大肠菌群可产生β-半乳糖苷酶,分解培养基中的酶底物-茜素-β-D-半乳糖苷(以下简称Aliz-gal),使茜素游离并与固体培养基中的铝、钾、铁、铵离子结合形成紫色(或红色)的鳌合物,使菌落呈现相应的颜色。
四、检验方法以及结果分析
4.1 多管发酵法
大肠菌群多管发酵法检验程序见图1。
图1 大肠菌群检验程序
4.1.1 矿泉水水源水检测
4.1.1.1 推测性检验
a) 吸取10mL水样接种到盛有10mL双料乳糖胆盐发酵培养液的试管中,共接种5份;
b) 吸取1mL水样接种到盛有10mL单料乳糖胆盐发酵培养液的试管中,共接种5份;
c) 吸取1mL水样接种到9mL灭菌生理盐水的试管中,混匀,用5mL灭菌吸管吸取5mL稀释液,分别加到5支盛有10mL单料乳糖胆盐发酵培养液的试管中,每管1mL(即0.1mL水样);
d) 轻摇试管,使液体充分混合,置36℃±1℃培养箱内培养25h。观察每管是否产气,若有气体产生该管则为推测性检验阳性,如不产气则为大肠菌群阴性。
质控菌株接种到乳糖胆盐发酵培养基管中,培养结果如下图所示:
图2 标准菌株在乳糖胆盐发酵培养基中生长情况
4.1.1.2 确证性试验
a) 自推测性检验阳性管中取一接种环培养液,接种到亮绿乳糖胆盐培养液(BGLB)管中,置36℃±1℃培养箱中培养48h;
b) 观察BGLB管中的产气情况,如有气体产生,就可确定为“大肠菌群阳性”;如无气体产生则为“大肠菌群阴性”。记下BGLB管里产气的阳性试管数,查MPN表可得出水样中大肠菌群的MPN值。
质控菌株接种到BGLB管中,培养结果如下图所示:
图3 大肠菌群在BGLB肉汤中生长情况
4.1.1.3 MPN值的计算
如水样含菌量少,也可按100mL、10mL、1mL接种,那么其实际MPN值应为表中的MPN值除以10;反之如含菌量较多,也可接种1mL、0.1mL、0.01mL,其实际MPN值应为表中的MPN值乘以10,余此类推。
4.1.1.4 列举说明
假设推测性检验15支试管中的阳性管数如下:①在接种量为10mL的管中有5支管阳性;②在接种量为1mL的管中有4支管阳性;③在接种量为0.1mL的管中有2支管阳性;
作为推测性检验结果为5-4-2。当把以上阳性管转种到BGLB管里,经培养后,作为证实性检验所给的结果如为5-3-1,那么查MPN表,就可知大肠菌群的MPN值为每100mL水样中110。接种量为100mL、10mL、1mL时,MPN值为11。如接种量为1mL、0.1mL、0.01mL时,MPN值即为1100。
表1 大肠菌群(MPN)检索表(部分)
(总接种量55.5mL,其中5份10mL水样、5份1mL水样、5份0.1mL水样)
4.1.2 直接饮用的矿泉水的检测
矿泉水出厂成品水或准备直接饮用的矿泉水,一般不应有污染,需要经常检验,可按下法进行接种。
4.1.2.1 推测性检验
a) 用10mL的灭菌吸管向5支盛有10mL双料乳糖胆盐发酵培养液的试管中,每管接种10mL水样。
b) 置36℃±1℃培养箱中培养24h,观察每支管的产气情况,如有气体产生,则认为推测性检验阳性。
4.1.2.2 确证性试验
操作步骤同矿泉水水源水检验。
4.1.2.3 MPN值的计算
当经过证实性检验后,5管10mL水样结果中,阳性反应的管数对应的MPN 值及其95%的可信限范围见表2。
表2 用5管10mL水样时各种阳性和阴性结果组合的MPN值及其95%的可信限
|
阳性反应管数 |
MPN/100mL |
95%可信限 |
|
|
下限 |
上限 |
||
|
0 |
0 |
0 |
6.0 |
|
1 |
2.2 |
0.1 |
12.6 |
|
2 |
5.1 |
0.5 |
19.2 |
|
3 |
9.2 |
1.6 |
29.4 |
|
4 |
16 |
3.3 |
56.9 |
|
5 |
>16 |
8.0 |
无限 |
4.2 滤膜法
4.2.1 操作步骤
4.2.1.1 用灭菌镊子夹取灭菌滤膜边缘部分,将粗糙面向上,贴放在已灭菌的滤床上,固定好滤器,将100mL水样(如水样含菌数较多,可减少过滤水样量,或将水样稀释)注入滤器中,打开滤器阀门,在-5.07×104 Pa(负0.5大气压)下抽滤。
4.2.1.2 水样滤完后,再抽气约5s,关上滤器阀门,取下滤器,用灭菌镊子夹取滤膜边缘部分,移放在品红亚硫酸钠培养基上,滤膜截留细菌面向上,滤膜应与培养基完全贴紧,两者间不得留有气泡,然后将平皿倒置,放入36℃±1℃恒温箱内培养24h±2h。
4.2.1.3 观察滤膜上面的菌落特征。大肠菌群典型菌落在远藤培养基上具有以下特征:
a) 紫红色,具有金属光泽的菌落;
b) 深红色,不带或略带金属光泽的菌落;
c) 淡红色,中心色较深的菌落;
d) 挑取不少于3个(不足3个则全挑)可疑菌落,进行革兰氏染色镜检观察。
质控菌株接种到品红亚硫酸钠培养基平板上,培养结果如下图所示:
图4 大肠菌群在品红亚硫酸钠培养基平板上生长情况
注:A:大肠埃希氏菌ATCC 25922;B:大肠埃希氏菌ATCC 8739;C:弗氏柠檬酸杆菌ATCC 43864
4.2.1.4 凡系革兰氏阴性无芽孢杆菌,再接种乳糖蛋白胨培养液,经36℃±1℃培养24h±2h后,如产酸产气则判定为大肠菌群阳性。
图5 大肠埃希氏菌ATCC 25922革兰氏染色镜检结果
图6 质控菌株在乳糖蛋白胨培养液中生长情况
4.2.2 结果与报告
滤膜上的大肠菌群菌落数按下列公式计算,以每100mL水样中的大肠菌群数报告结果:
每100mL水样中大肠菌群菌落数(CFU/100mL)=确证为大肠菌群菌落数(CFU)×100/过滤的试样量(mL)
举例说明:
滤膜上有100个典型菌落,挑取10个典型菌落(可疑菌落)做革兰氏染色镜检,发现有8个菌落为革兰氏阴性无芽孢杆菌,这8个菌落接种乳糖蛋白胨培养液,培养后,有6支管产酸产气,为大肠菌群阳性。
则每100mL水样中大肠菌群菌落数为:(100×6/10×100)/100=60(CFU/100mL)
相关产品:
注:本文属海博生物原创,未经允许不得转载。
上一篇:大肠菌群的快速检测方法及结果判断
